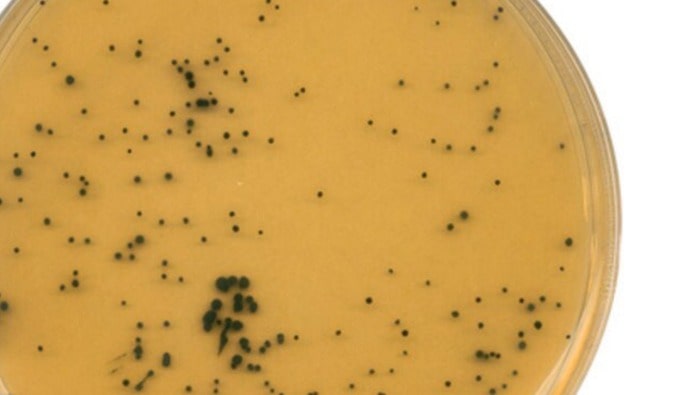

TS 1330 - Yogurtda kislotalikni aniqlash KO'PROQ O'QING

BLOG

TS 1330 - Yogurtda kislotalikni aniqlash KO'PROQ O'QING
ISO 7937: Oziq-ovqat va hayvonlarni oziqlantirish mikrobiologiyasi - Clostridium perfringensni ro'yxatga olishning gorizontal usuli - Koloniyani hisoblash texnikasi KO'PROQ O'QING

ISO 16654: Oziq-ovqat va hayvonlarni oziqlantirish mikrobiologiyasi - Escherichia coli ni aniqlashning gorizontal usuli 0157 KO'PROQ O'QING

TS EN ISO 7251: Oziq-ovqat va hayvonlarni oziqlantirish mikrobiologiyasi - Escherichia coli ni aniqlash va sanab o'tishning gorizontal usuli - Eng mumkin bo'lgan raqam texnikasi KO'PROQ O'QING

ISO 4832: Oziq-ovqat va hayvonlarni oziqlantirish mikrobiologiyasi - Koliformlarni ro'yxatga olishning gorizontal usuli - Koloniyalarni hisoblash texnikasi KO'PROQ O'QING

ISO 11290-1: Oziq-ovqat zanjirining mikrobiologiyasi - Listeria monocytogenes va Listeria spp. ni aniqlash va sanab o'tishning gorizontal usuli. — 1-qism: Aniqlash usuli KO'PROQ O'QING